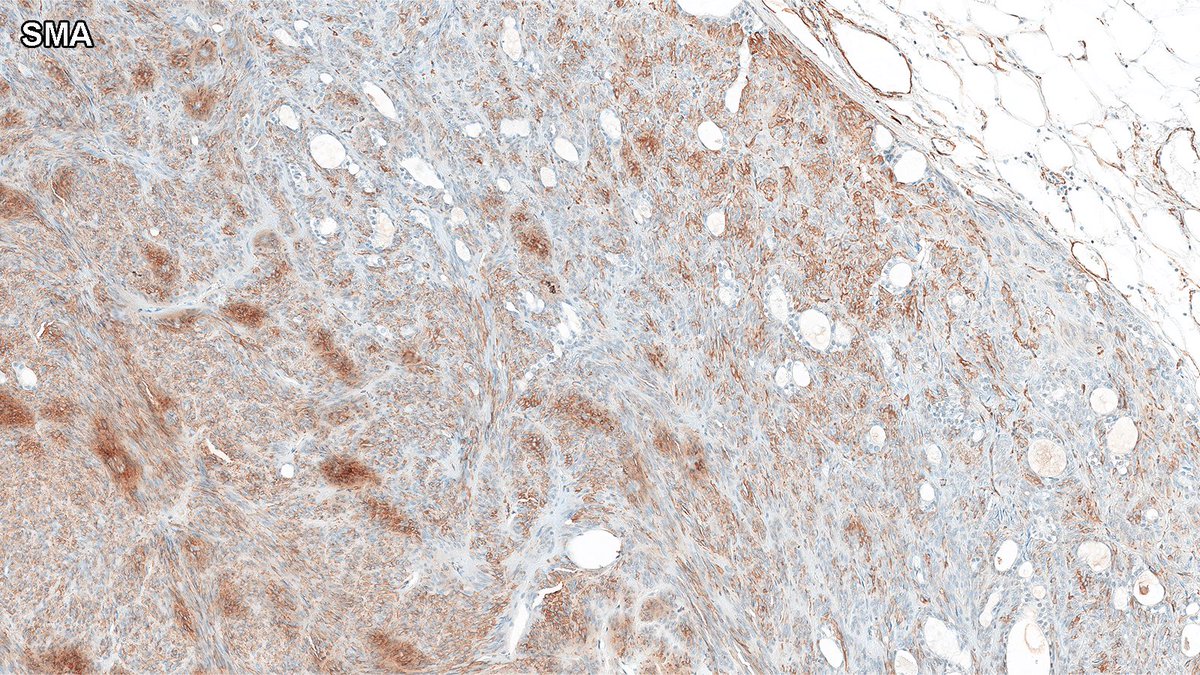
Crushed it! 🎯
The answer: adenomyoepithelioma (AME).

AME can sometimes take on a more spindled morphology, as in this case. Shown here: SMA immunohistochemistry 👇

#PathX #PathTwitter #breastpath #PathQuiz

A. Polónia
@poloniaantonio
MD PhD #breastpath #gupath #gynpath Co-Chair Computational Working Group-ESP
ID: 1152209970378805250
https://www.linkedin.com/in/ant%C3%B3nio-pol%C3%B3nia-06ab545b/ 19-07-2019 13:33:58
11,11K Tweet
3,3K Takipçi
1,1K Takip Edilen





PATHART OF THE DAY!🙂 This SebK sure decided to take on a funny shape.Sanjay Mukhopadhyay Jerad Gardner, MD Pepe Jiménez Heffernan Anupama Arya Celina Stayerman MD Ari M Lorand Kis Kemal Kösemehmetoğlu Vijay Shankar S Vidya Monappa Carol N. Rizkalla, MD Dan Graham Miruna Popescu, MD #pathart #dermpath #pareidolia








Hello Friends! I'm writing to invite you to our 1st AIMM Journal Club-live on Microsoft Teams this Thursday, August 28th @ 7 pm EST. We've invited the authors of 2 recent great papers to present. Katrina Collins, MD || Pathologist & I will moderate attendee Q&A. Register here: tinyurl.com/ycxeye84